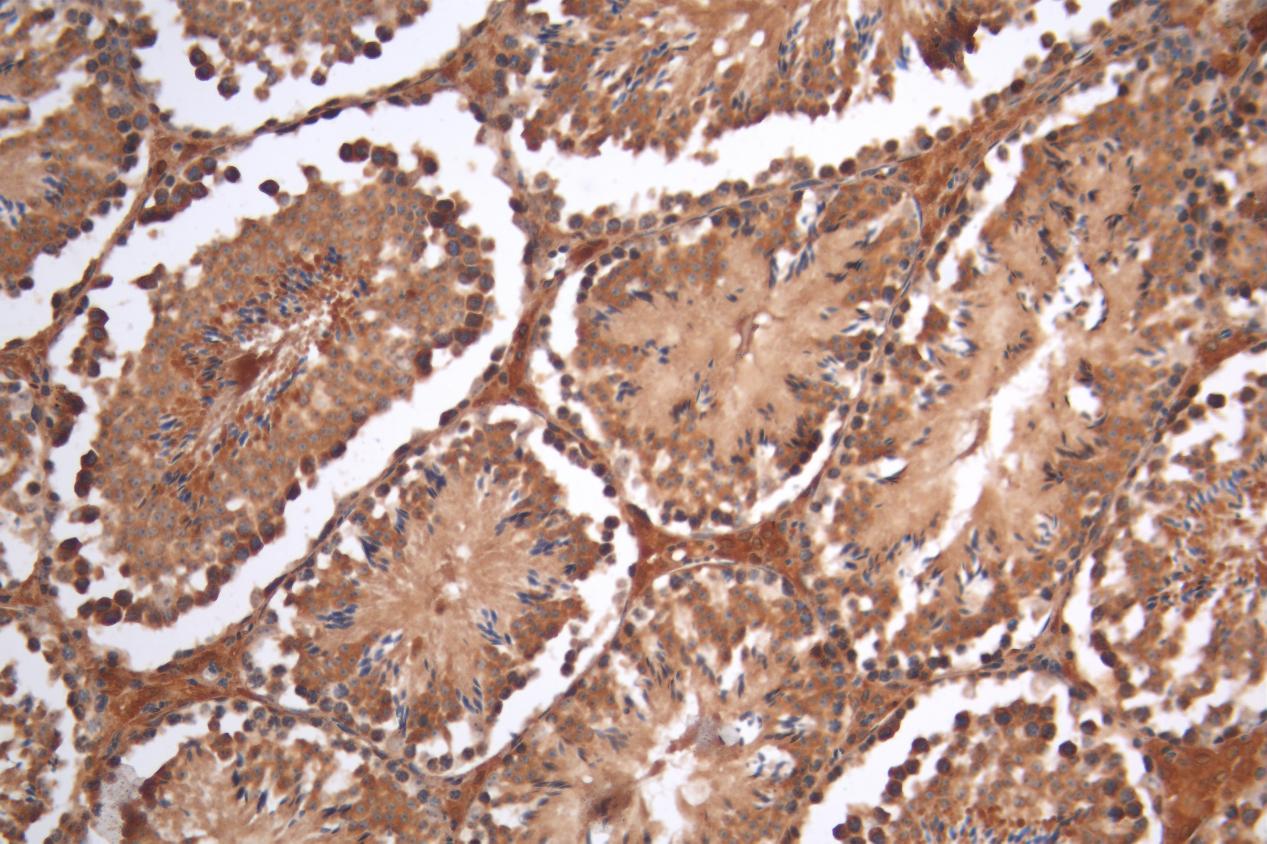

SMOC1 Antibody
-
中文名稱:SMOC1兔多克隆抗體
-
貨號:CSB-PA875673LA01HU
-
規格:¥440
-
圖片:
-
IHC image of CSB-PA875673LA01HU diluted at 1:200 and staining in paraffin-embedded human testis tissue performed on a Leica BondTM system. After dewaxing and hydration, antigen retrieval was mediated by high pressure in a citrate buffer (pH 6.0). Section was blocked with 10% normal goat serum 30min at RT. Then primary antibody (1% BSA) was incubated at 4°C overnight. The primary is detected by a Goat anti-rabbit polymer IgG labeled by HRP and visualized using 0.05% DAB.
-
-
其他:
產品詳情
-
產品名稱:Rabbit anti-Homo sapiens (Human) SMOC1 Polyclonal antibody
-
Uniprot No.:
-
基因名:
-
別名:Secreted modular calcium-binding protein 1 antibody; SMOC-1 antibody; SMOC1 antibody; SMOC1_HUMAN antibody; SPARC-related modular calcium-binding protein 1 antibody
-
宿主:Rabbit
-
反應種屬:Human
-
免疫原:Recombinant Human SPARC-related modular calcium-binding protein 1 protein (277-382AA)
-
免疫原種屬:Homo sapiens (Human)
-
標記方式:Non-conjugated
本頁面中的產品,SMOC1 Antibody (CSB-PA875673LA01HU),的標記方式是Non-conjugated。對于SMOC1 Antibody,我們還提供其他標記。見下表:
-
克隆類型:Polyclonal
-
抗體亞型:IgG
-
純化方式:>95%, Protein G purified
-
濃度:It differs from different batches. Please contact us to confirm it.
-
保存緩沖液:Preservative: 0.03% Proclin 300
Constituents: 50% Glycerol, 0.01M PBS, PH 7.4 -
產品提供形式:Liquid
-
應用范圍:ELISA, IHC
-
推薦稀釋比:
Application Recommended Dilution IHC 1:20-1:200 -
Protocols:
-
儲存條件:Upon receipt, store at -20°C or -80°C. Avoid repeated freeze.
-
貨期:Basically, we can dispatch the products out in 1-3 working days after receiving your orders. Delivery time maybe differs from different purchasing way or location, please kindly consult your local distributors for specific delivery time.
-
用途:For Research Use Only. Not for use in diagnostic or therapeutic procedures.
相關產品
靶點詳情
-
功能:Plays essential roles in both eye and limb development. Probable regulator of osteoblast differentiation.
-
基因功能參考文獻:
- Missense mutation in exon 3 of SMOC1 segregated with the Waardenburg anophthalmia syndrome in the Iranian family. PMID: 28807869
- This is the first report of Waardenburg anophthalmia syndrome (WAS) caused by a SMOC1 variant in a Pakistani population. The mutation identified in the present investigation extends the body of evidence implicating the gene SMOC-1 in causing WAS. PMID: 28085523
- SMOC binds to Pro-EGF, but does not induce Erk phosphorylation via the EGFR. PMID: 27101391
- IL-17A but not IL-22 suppresses the replication of hepatitis B virus by inducing the expression of MxA and OAS. PMID: 23274784
- SMOC1 provides a link between prenatal hormone exposure and digit ratio. PMID: 23263445
- Homozygosity mapping and subsequent targeted mutation analysis of a locus on 14q24.2 identified homozygous mutations in SMOC1 (SPARC-related modular calcium binding 1) in eight unrelated families with Waardenburg Anophthalmia syndrome. PMID: 21750680
- The present study thus identified SPARC related modular calcium binding 1 as a new cancer-associated protein capable of interacting with tenascin-C in vitro PMID: 21349332
- these findings indicate that SMOC1/Smoc1 is essential for ocular and limb development in both humans and mice. PMID: 21194678
- Waardenburg anophthalmia syndrome is genetically heterogeneous; a second was locus found on chromosome 14, and mutations in SMOC1 were shown also cause this syndrome. PMID: 21194680
- Analyzed the secretory protein profiles of BMSCs grown in osteogenic medium (OSM) and identified SPARC-related modular calcium-binding protein 1 (SMOC1), a member of the SPARC family, as a regulator of osteoblast differentiation of BMSCs. PMID: 20359165
- isolation of the novel gene SMOC-1 encoding a secreted modular protein containing an EF-hand calcium-binding domain; localization within basement membranes in kidney and skeletal muscle and expression in the zona pellucida surrounding the oocyte PMID: 12130637
- SMOC-1 is of physiological interest because it codes a secreted glycoprotein with five domains, each containing regions homologous to those on other proteins that mediate cell-matrix interactions. PMID: 17386346
顯示更多
收起更多
-
相關疾病:Ophthalmoacromelic syndrome (OAS)
-
亞細胞定位:Secreted, extracellular space, extracellular matrix, basement membrane. Note=In or around the basement membrane.
-
組織特異性:Widely expressed in many tissues with a strongest signal in ovary. No expression in spleen.
-
數據庫鏈接:
Most popular with customers
-
-
YWHAB Recombinant Monoclonal Antibody
Applications: ELISA, WB, IHC, IF, FC
Species Reactivity: Human, Mouse, Rat
-
Phospho-YAP1 (S127) Recombinant Monoclonal Antibody
Applications: ELISA, WB, IHC
Species Reactivity: Human
-
-
-
-
-